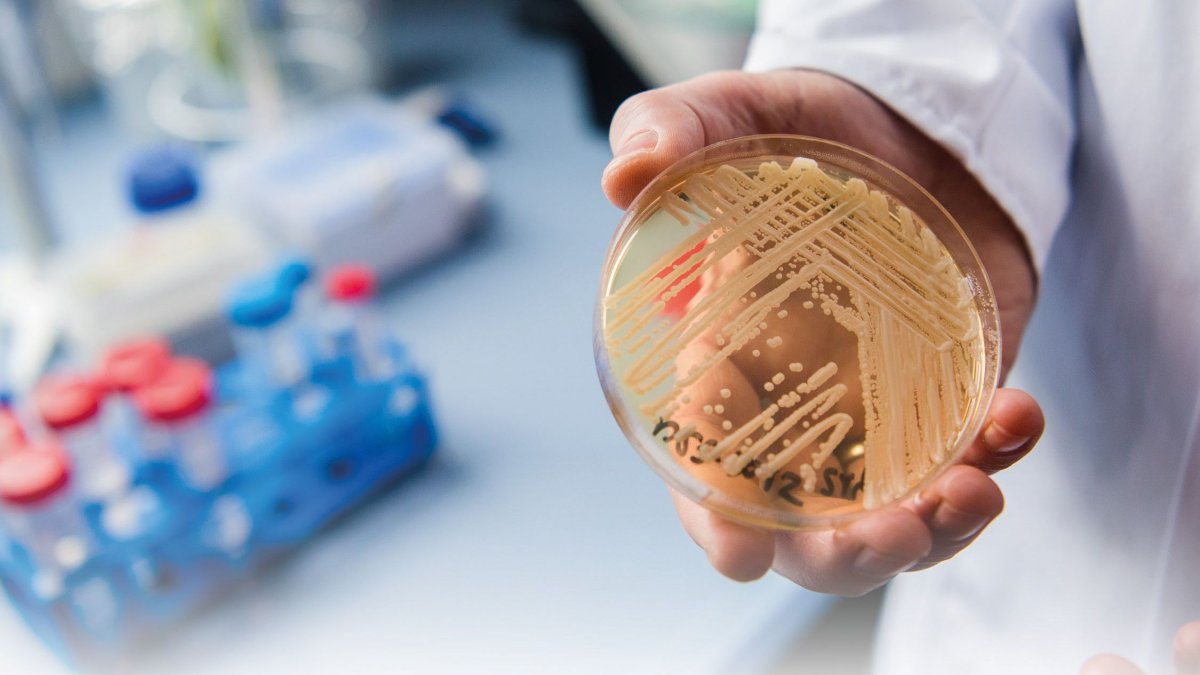
ΕΟΔΥ: «Αυτή τη στιγμή δεν έχουμε κάποια ενεργή συρροή από Candida auris»

Αυτή τη στιγμή δεν έχουμε κάποια ενεργή συρροή από Candida Auris που να μας έχει δηλωθεί, να είμαστε σε εγρήγορση και να διερευνάται από τον ΕΟΔΥ, δηλώνει στο Πρακτορείο Fm και η προϊσταμένη Διεύθυνσης Επιδημιολογικής Επιτήρησης για τα λοιμώδη Νοσήματα του ΕΟΔΥ, επιδημιολόγος κ. Κασσιανή Μέλλου, μετά την ανησυχία που προκλήθηκε από δηλώσεις επιστημόνων περί εντοπισμού του συγκεκριμένου παθογόνου στον Ευαγγελισμό και άλλα νοσοκομεία της Αθήνας.
Η κ. Μέλλου διευκρινίζει ωστόσο ότι σχεδόν σε όλες τις μονάδες έχουν υπάρξει κατά καιρούς παθογόνα που έχουν μεταδοθεί ενδονοσοκομειακά. «Δεν υπάρχει μονάδα εντατικής θεραπείας διεθνώς που να είναι αποστειρωμένη, χωρίς κανένα παθογόνο. Και για να εκφράσω και την προσωπική μου άποψη, θα προτιμούσα να πάω σε ένα νοσοκομείο όπως ο Ευαγγελισμός, που έχει ανακοινώσει ότι έχει βρει candida στο παρελθόν, γιατί αυτό σημαίνει ότι οι γιατροί είναι ενημερωμένοι για να το ψάξουν, έχουν την εργαστηριακή δυνατότητα, και έλαβαν γρήγορα μέτρα για να μην έχουμε κάποια μεγάλη συρροή. Είναι σημαντικό να γνωρίζουμε ότι πολλές φορές, υπηρεσίες που μας δηλώνουν ότι έχουν κρούσματα δεν είναι αυτές που είναι πιο επικίνδυνες».
Όσον αφορά δηλώσεις με τις οποίες συσχετίζεται ο συγκεκριμένος μύκητας με θανάτους στην Πάτρα, η εκπρόσωπος του ΕΟΔΥ σημειώνει: «Δεν υπήρξε κάποια επίσημη επιβεβαίωση αυτής της δήλωσης, ούτε έχει δηλωθεί κάποιος θάνατος που να έχει αποδοθεί στην candida στην Πάτρα, και να το γνωρίζουμε».
Έχει παρατηρηθεί αύξηση του εν λόγω παθογόνου στην πανδημία που οι εντατικές επιβαρύνθηκαν όσο ποτέ; προκύπτει εύλογα το ερώτημα. «Διεθνώς υπάρχουν κάποια δεδομένα που μιλούν για αύξηση. Θα ήθελα όμως να διευκρινίσω, ότι είναι πολύ σημαντικό το γεγονός ότι υπάρχει δυσκολία στη διάγνωση της candida. Έτσι τα τελευταία χρόνια έχουμε βελτιώσει την εργαστηριακή μας διερεύνηση και βρίσκουμε πιο εύκολα το συγκεκριμένο παθογόνο. Κατά συνέπεια η αυξημένη ανίχνευση του, δεν σημαίνει κατ’ ανάγκη αύξηση. Αλλά σημαίνει ότι είμαστε πιο ενημερωμένοι, και ότι οι γιατροί ψάχνουν όταν έχουν κρούσματα, και για candida».
Ο μύκητας Candida Auris, ο οποίος εμφανίζεται συνήθως στους νοσοκομειακούς χώρους και κυρίως στις μονάδες εντατικής θεραπείας, δεν απειλεί άτομα εκτός νοσοκομείου και εκτός ΜΕΘ, ξεκαθαρίζει η κ. Μέλλου για να προσθέσει στη συνέχεια ότι όσο πιο ανοσοκατεσταλμένος είναι κάποιος, ή φέρει ξένα σώματα, όπως πχ καθετήρα ή είναι διασωληνωμένος, αυξάνεται η πιθανότητα να αποκτήσει σοβαρή νόσηση από τον συγκεκριμένο μύκητα.
«Αυτό που θα ήθελα να διευκρινίσω, επειδή τις τελευταίες ημέρες έχει γίνει πολλή συζήτηση για αυτόν τον μύκητα, είναι ότι ουσιαστικά αποτελεί ένα από τα παθογόνα που μπορεί να προκύψει μέσα σε μία ΜΕΘ, και να οδηγήσει σε νοσοκομειακή λοίμωξη, αλλά δεν είναι το μοναδικό.
Δεν θα ήθελα να χάσουμε την εικόνα λόγω της δημοσιότητας που έχει πάρει το θέμα. Όλες οι λοιμώξεις που μπορεί να προκύψουν μέσα σε μία μονάδα εντατικής θεραπείας είναι σημαντικές. Σαφώς για όλες, μας ενδιαφέρει να πάρουμε άμεσα μέτρα και σε όλες τα μέτρα είναι τα ίδια, είτε είναι candida, είτε ψευδομονάδα, είτε κάποιο άλλο παθογόνο. Πρέπει να έχουμε πολύ καλή τήρηση των συνθηκών υγιεινής».
Το 2019 απομονώθηκε για πρώτη φορά candida στη χώρα μας, αναφέρει η κ. Μέλλου εξηγώντας ότι αυτό οδήγησε σε μία πιλοτική εφαρμογή (2019-2021) για ενημέρωση των νοσοκομείων σχετικά με το παθογόνο.
«Είχαν σταλεί αρκετές φορές υπηρεσιακά σημειώματα ενημέρωσης από μας προς τους γιατρούς των μονάδων για την πιθανότητα εμφάνισης του παθογόνου, πώς θα πρέπει εργαστηριακά να το ελέγχουν, και να μας δηλώνουν κρούσματα. Έτσι πιλοτικά είχαμε καταγράψει μέσα σε αυτά τα χρόνια, (και εν μέσω πανδημίας) κάποια κρούσματα, τα οποία δεν οδήγησαν σε κάποια τραγικά μεγάλη συρροή. Παρόλα αυτά αποφασίσαμε να υπάρξει μία ολική πλέον καταγραφή, να υπάρξει υποχρεωτική δήλωση αυτών των λοιμώξεων.
Πλέον έχουμε και την εργαστηριακή δυνατότητα διερεύνησης στα νοσοκομεία και έχουμε και εργαστήριο στο ΕΚΠΑ που μπορεί να επιβεβαιώσει ότι πρόκειται για candida. Κατόπιν όλων αυτών ο candida auris έχει εισαχθεί στη λίστα των παθογόνων που καταγράφουμε πιά τακτικά από όλες τις ΜΕΘ της χώρας. Αυτό έχει εγκριθεί και από τον υπουργό κ. Πλεύρη (είναι γνωστή η ευαισθησία του στο θέμα, λόγω και της προσωπικής του περιπέτειας με ενδονοσοκομειακή λοίμωξη) και αποτελεί την πρώτη προτεραιότητα για τον ΕΟΔΥ. Τους επόμενους μήνες θα κοινοποιηθούν και τα αποτελέσματα».
Tο pronews.gr δημοσιεύει κάθε σχόλιο το οποίο είναι σχετικό με το θέμα στο οποίο αναφέρεται το άρθρο. Ο καθένας έχει το δικαίωμα να εκφράζει ελεύθερα τις απόψεις του. Ωστόσο, αυτό δεν σημαίνει ότι υιοθετούμε τις απόψεις αυτές και διατηρούμε το δικαίωμα να μην δημοσιεύουμε συκοφαντικά ή υβριστικά σχόλια όπου τα εντοπίζουμε. Σε κάθε περίπτωση ο καθένας φέρει την ευθύνη των όσων γράφει και το pronews.gr ουδεμία νομική ή άλλα ευθύνη φέρει.
Δικαίωμα συμμετοχής στη συζήτηση έχουν μόνο όσοι έχουν επιβεβαιώσει το email τους στην υπηρεσία disqus. Εάν δεν έχετε ήδη επιβεβαιώσει το email σας, μπορείτε να ζητήσετε να σας αποσταλεί νέο email επιβεβαίωσης από το disqus.com
Όποιος χρήστης της πλατφόρμας του disqus.com ενδιαφέρεται να αναλάβει διαχείριση (moderating) των σχολίων στα άρθρα του pronews.gr σε εθελοντική βάση, μπορεί να στείλει τα στοιχεία του και στοιχεία επικοινωνίας στο info3@pronews.gr και θα εξεταστεί άμεσα η υποψηφιότητά του.